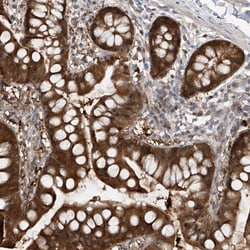
Invitrogen TTC38 Polyclonal Antibody 100 &mu;L | Buy Online | Invitrogen&trade; | Fisher Scientific

missing translation for 'onlineSavingsMsg'
Learn More
Learn More
Invitrogen™ TTC38 Polyclonal Antibody


Description
Immunogen sequence: PGENCQHLLA RDVGLPLCQA LVEAEDGNPD RVLELLLPIR YRIVQLGGSN AQRDVFNQLL IHAALNCTSS VHKNVARSLL MERDALKPNS PLTERLIRKA ATVHLM Highest antigen sequence identity to the following orthologs: Mouse - 92%, Rat - 91%.
Specifications
Specifications
| Antigen | TTC38 |
| Applications | Immunohistochemistry (Paraffin), Western Blot, Immunocytochemistry |
| Classification | Polyclonal |
| Concentration | 0.30 mg/mL |
| Conjugate | Unconjugated |
| Formulation | PBS with 40% glycerol and 0.02% sodium azide; pH 7.2 |
| Gene | TTC38 |
| Gene Accession No. | Q5R3I4 |
| Gene Alias | 9030019H09; LL22NC03-5H6.5; RGD1306041; tetratricopeptide repeat domain 38; tetratricopeptide repeat protein 38; TPR repeat protein 38; TTC38 |
| Gene Symbols | TTC38 |
| Show More |